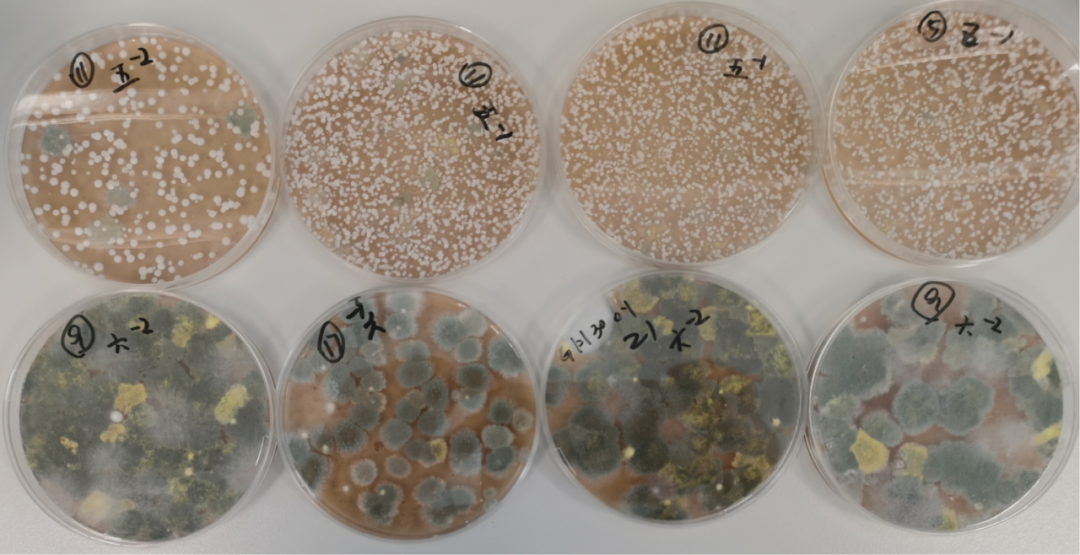
大曲质量与微生物组的内在联系

微生物如何影响不同香型的白酒
2024-06-26中国白酒行业尽管市场规模巨大,然而当前正面临着劳动力资源短缺、人工成本上涨、生产效率偏低以及国际市场份额低等多重挑战。传统的白酒酿造工艺在很大程度上依赖于自然发酵和人工经验,这在一定程度上导致了原酒品质的不稳定。
应对挑战,中国白酒行业正积极推动标准化、机械化、自动化及智能化的发展进程。这一转型旨在通过科学原理指导生产工艺,实现生产流程的标准化,从而降低成本,提升劳动生产率。

在2024年酿酒微生物制剂应用技术论坛上,中国科学院真菌地衣系统学重点实验室副主任白逢彦研究员,对不同香型白酒酿造过程与周边自然环境微生物组的比较研究进行了深入阐述,为揭示白酒酿造的奥秘提供了科学的理论支撑。
白酒发酵工艺的优化与升级:白酒酿造科学机理的深度研究
传统的白酒发酵过程是一个复杂的微生物共生代谢过程,即“多微共酵”。白教授强调,深入研究白酒酿造微生物组是揭开酿造机理的关键所在。通过对微生物种类构成、群落演替以及不同种类微生物的功能进行深入研究,可以为优化和升级发酵工艺提供科学的理论支撑。
白教授首先介绍了其团队在微生物组全程跟踪方面的研究策略,包括根据温度变化曲线进行密集采样,并同步综合分析理化特性、酶学特征和风味物质。通过培养组和宏基因组分析,可以更加深入地理解微生物群落的构成和演替规律。

不同香型白酒微生物群落的对比分析
研究结果显示,清香型、浓香型和酱香型白酒的大曲微生物群落存在显著的差异。这些差异不仅体现在微生物的种类和数量上,还体现在它们的功能和相互作用上。例如,低温大曲、中温大曲和高温大曲的最高发酵温度各不相同,从而影响了微生物群落的构成。

大曲质量与微生物组的内在联系
白教授团队从全国10个省份的53个厂家共采集了296份大曲样品,进行了好曲与差曲的微生物组对比研究。研究指出,不同质量的大曲在微生物组构成上存在显著差异,好曲在微生物含量、功能微生物含量以及微生物网络结构上均优于差曲。这一发现为大曲质量的客观评价提供了重要的科学依据。

传统与机械化酿造微生物组的差异研究
白教授还探讨了传统酿造与机械化酿造在微生物组构成上的差异。研究发现,机械化堆积过程中的高温环境对酵母菌的生长不利,而传统堆积方式则更有利于维持微生物的多样性和平衡。
酿造环境与自然环境的微生物关联性分析
此外,白教授还深入探讨了酿造环境与周边自然环境微生物的关系。他指出,不同地区的气候和生态环境孕育了不同的微生物区系,进而影响了白酒的风味多样性。例如,茅台镇的特殊气候和生态环境为茅台酒的独特风味提供了坚实的基础。

通过对白酒酿造过程中微生物组的深入研究,我们可以更加清晰地理解不同香型白酒的风味形成机制,为白酒的生产和品质提升提供科学的理论依据。同时,也为传统酿造工艺的现代化和国际化发展提供了新的思路和方法。
微生物如何影响不同香型的白酒
2024-06-26中国白酒行业尽管市场规模巨大,然而当前正面临着劳动力资源短缺、人工成本上涨、生产效率偏低以及国际市场份额低等多重挑战。传统的白酒酿造工艺在很大程度上依赖于自然发酵和人工经验,这在一定程度上导致了原酒品质的不稳定。
应对挑战,中国白酒行业正积极推动标准化、机械化、自动化及智能化的发展进程。这一转型旨在通过科学原理指导生产工艺,实现生产流程的标准化,从而降低成本,提升劳动生产率。

在2024年酿酒微生物制剂应用技术论坛上,中国科学院真菌地衣系统学重点实验室副主任白逢彦研究员,对不同香型白酒酿造过程与周边自然环境微生物组的比较研究进行了深入阐述,为揭示白酒酿造的奥秘提供了科学的理论支撑。
白酒发酵工艺的优化与升级:白酒酿造科学机理的深度研究
传统的白酒发酵过程是一个复杂的微生物共生代谢过程,即“多微共酵”。白教授强调,深入研究白酒酿造微生物组是揭开酿造机理的关键所在。通过对微生物种类构成、群落演替以及不同种类微生物的功能进行深入研究,可以为优化和升级发酵工艺提供科学的理论支撑。
白教授首先介绍了其团队在微生物组全程跟踪方面的研究策略,包括根据温度变化曲线进行密集采样,并同步综合分析理化特性、酶学特征和风味物质。通过培养组和宏基因组分析,可以更加深入地理解微生物群落的构成和演替规律。

不同香型白酒微生物群落的对比分析
研究结果显示,清香型、浓香型和酱香型白酒的大曲微生物群落存在显著的差异。这些差异不仅体现在微生物的种类和数量上,还体现在它们的功能和相互作用上。例如,低温大曲、中温大曲和高温大曲的最高发酵温度各不相同,从而影响了微生物群落的构成。

大曲质量与微生物组的内在联系
白教授团队从全国10个省份的53个厂家共采集了296份大曲样品,进行了好曲与差曲的微生物组对比研究。研究指出,不同质量的大曲在微生物组构成上存在显著差异,好曲在微生物含量、功能微生物含量以及微生物网络结构上均优于差曲。这一发现为大曲质量的客观评价提供了重要的科学依据。
传统与机械化酿造微生物组的差异研究
白教授还探讨了传统酿造与机械化酿造在微生物组构成上的差异。研究发现,机械化堆积过程中的高温环境对酵母菌的生长不利,而传统堆积方式则更有利于维持微生物的多样性和平衡。
酿造环境与自然环境的微生物关联性分析
此外,白教授还深入探讨了酿造环境与周边自然环境微生物的关系。他指出,不同地区的气候和生态环境孕育了不同的微生物区系,进而影响了白酒的风味多样性。例如,茅台镇的特殊气候和生态环境为茅台酒的独特风味提供了坚实的基础。

通过对白酒酿造过程中微生物组的深入研究,我们可以更加清晰地理解不同香型白酒的风味形成机制,为白酒的生产和品质提升提供科学的理论依据。同时,也为传统酿造工艺的现代化和国际化发展提供了新的思路和方法。